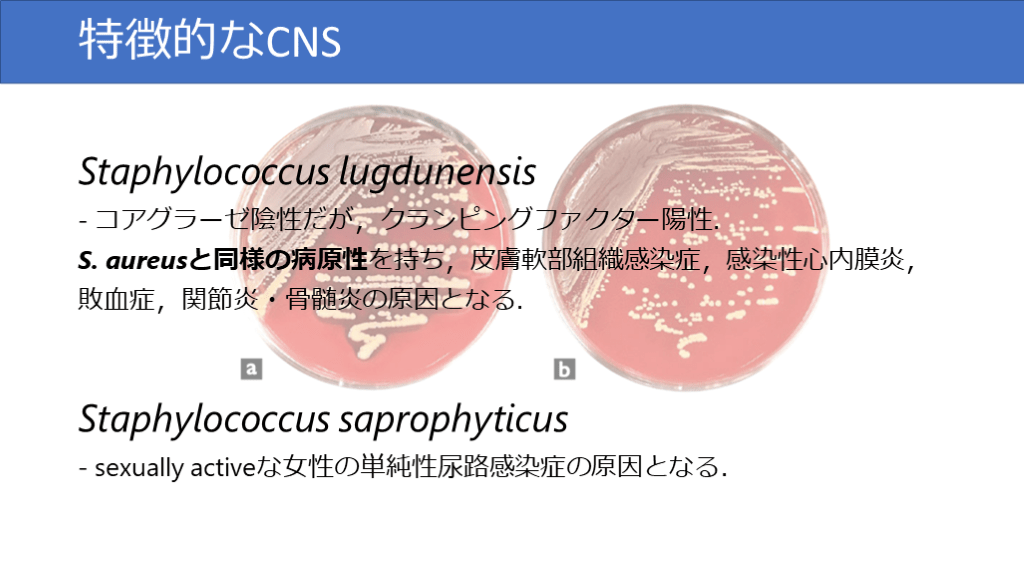

1/43
関連するスライド
2022.12.30更新 細菌感染症の治療期間まとめ
新米ID
102081
980
連鎖球菌よもやま
長谷川耕平
256258
323
【デキレジ】神経症候④不眠
やまて
509778
1729
ミニマム緑膿菌
高野哲史
55609
175
グラム陽性球菌
129,982
336
概要
日常診療で出会うことの多いグラム陽性球菌についての所属施設での初期研修医〜後期研修医向けのレクチャーのスライドを共有いたします.
最近改訂された感染性心内膜炎のDuke-ISCVID基準などにも触れながら,グラム陽性球菌の実践的な分類と臨床上の注意点(特に感染性心内膜炎の合併の可能性について)について解説しています.
本スライドの対象者
研修医/専攻医/専門医
投稿された先生へ質問や勉強になったポイントをコメントしてみましょう!
0 件のコメント
このスライドと同じ診療科のスライド
テキスト全文
グラム陽性球菌の基礎知識
#1.
グラム陽性球菌 板橋中央総合病院 鵜飼康平
#2.
こんなことないですか? ・「血液培養でグラム陽性球菌が出ました」と電話を受けた ・尿培養がまだ中間報告だけどグラム陽性球菌と書いてある ・喀痰培養にグラム陽性球菌2+と書いてある →今日の講義は「鑑別診断」を意識しながら,「グラム陽性球菌」のままで終わらせずに微生物名を突き詰めることを目標にしています
#3.
細菌っていろんな種類があります
#4.
グラム陽性球菌
細菌検査の流れとS. aureusの感染症
#5.
細菌検査の流れ 細菌検査は3段階 1. 塗抹 2. (平板)培養 3. 感受性試験※血液培養は,1. ボトル培養 2. 塗抹 3. 平板培養 4. 感受性試験 数時間〜72時間(菌種による) 検体採取日(day0)- 塗抹検査- 培地への接種 検査採取日(day1)- 培地のコロニー確認- 同定検査- 感受性結果実施 検査採取日(day2)- 感受性結果確認
#6.
黄色ブドウ球菌 Staphylococcus aureus 皮膚,上気道,消化管,生殖器に常在している.グラム染色では菌が大きく,立体的.また菌体周囲にピンク色のフィブリン膜を生じる.
#7.
「皮膚,血流,関節・骨,人工物」を好みます. 皮膚 蜂窩織炎・NSTI CRBSI 化膿性血栓性静脈炎 菌血症 感染性心内膜炎化膿性関節炎 硬膜外膿瘍 膿胸化膿性椎体炎 髄膜炎 腸腰筋膿瘍骨髄炎 感染性動脈瘤 S. aureusが起こす感染症 Clin Microbiol Rev. 2019;32(2):e00041-18.
#8.
クイズ S. aureus菌血症(SAB)を見たらまずやることは? ? ? ? ? ? ?
#9.
クイズ答え SAB bundle S. aureus菌血症(SAB)を見たらまずやることは? 血液培養2セット再検(有効な抗菌薬開始48~96時間後) 経胸壁心エコー VCM投与 カテーテル抜去(CRBSIであれば) ドレナージ(膿瘍,関節炎,椎体炎)(遠隔病変検索のために造影CTやMRIなど) 感染症内科コンサルト Clin Infect Dis. 2013;57(9):1225-33.
#10.
SABの治療 MSSAであればCEZ,MRSAであればVCMが第一選択治療期間は血液培養陰転化から4週間が基本感染性心内膜炎,椎体炎,膿瘍,化膿性血栓性静脈炎などの合併症があれば6週間以上 umcomplicated SABであれば血液培養陰転化から2週間 全ての人工物や血管内カテーテルが除去されている IEが除外されている 初回から2-4日後の血液培養が陰性であること 治療開始から72時間以内に解熱 遠隔病変なし
コアグラーゼ陰性ブドウ球菌の特徴と感染症
#11.
コアグラーゼ陰性ブドウ球菌 CNS皮膚,消化管,生殖器に常在している.グラム染色は菌が小さく,「田」の形のように平面的
#12.
CNSが起こす感染症 ほとんどがCRBSI JAID/JSC 感染症治療ガイドライン 2017―敗血症およびカテーテル関連血流感染症― 短期カテーテルの場合 長期カテーテルの場合
#13.
クイズ Q. CRBSIを疑うけど,MRSAのリスクは高くないとき,empiric therapyをCEZで開始しても良いでしょうか?A. VCMを開始しましょう! CEZ VCM JANISサーベイランスと当院のアンチバイオグラムを元にしています
#14.
特徴的なCNS Staphylococcus lugdunensis- コアグラーゼ陰性だが,クランピングファクター陽性.S. aureusと同様の病原性を持ち,皮膚軟部組織感染症,感染性心内膜炎,敗血症,関節炎・骨髄炎の原因となる. Staphylococcus saprophyticus- sexually activeな女性の単純性尿路感染症の原因となる.
溶連菌の種類と感染症の概要
#15.
A群溶連菌 Streptococcus pyogenes上気道に常在している.グラム染色では菌周囲に赤みを帯びる.形は真円に近い. B群溶連菌 Streptococcus agalactiae膣内,消化管に常在している.グラム染色では大きめで丸みを帯びる.2~4連鎖と短め. C,G群溶連菌 Streptococcus dysgalactiae皮膚に常在している.グラム染色では6連鎖以上と長めで菌体も楕円に近い.
#16.
β溶血性連鎖球菌が起こす感染症 https://www.amboss.com/us/knowledge/Toxic_shock_syndrome
#17.
肺炎球菌Streptococcus pneumoniae口腔内や上気道に常在している.グラム染色では双球菌で周囲に莢膜を生じるため菌体周囲は染色されない,あるいは赤く見える.
#18.
S. pneumoniaeが引き起こす感染症 「肺炎,髄膜炎,敗血症」
#19.
髄膜炎のempiric therapyでVCMを使う理由 髄膜炎以外での肺炎球菌の治療髄膜炎でのPCG感受性株の肺炎球菌の治療 Performance Standards for Antimicrobial Susceptibility Testing, 27th ed. M100-S27. CLSI PCG 👍
#20.
α溶血連鎖球菌viridans group Streptococcus口腔内,消化管に常在している. (写真はStreptococcus oralis)グラム染色では6連鎖以上になることが多く,血液培養ボトルの溶血はβ溶血連鎖球菌よりは軽度.
腸球菌の特徴と関連する感染症
#21.
α/γ溶血性連鎖球菌 α溶血性:不完全な溶血で生じる緑色の変色帯に囲まれるγ溶血性:溶血性を示さない→菌としての特徴は似ている. mitis group, mutans groupなど・感染性心内膜炎・歯性感染症anginosus group・肺膿瘍/膿胸 Circulation. 2020;142:720–730.
#22.
StreptococcusごとにIEのリスクは違う Circulation. 2020;142:720–730.
#23.
Enterococcus faecalis腸管,膣に常在している.グラム染色は2~5連鎖と短め. Enterococcus faecium腸管,膣に常在している.グラム染色は2~8連鎖と短め.
#24.
Enterococcusが起こす感染症 「肝胆道系(腹腔内),尿路,感染性心内膜炎」など ただし,尿培養から分離されても尿路感染症を起こしていないことが多いという特徴がある. E. faecalisを含め多くの腸球菌はペニシリン系に感受性であり,ABPCが第一選択.E. faeciumはVCMなど抗MRSA薬のみ有効 - 腸球菌にはセフェム系は内因性に耐性 Clin Microbiol Rev. 1990;3(1):46-65.
血液培養の結果と真の菌血症の判断
#25.
まとめ CEZ VCM PCG(場合によってABPC, CTRX, VCM)
#26.
クイズ 血液培養1/2セットから発育したときに真の菌血症(>コンタミ)と考えられるのはどれでしょう? S. aureus CNS β-Streptococcus(GAS, GBS, GGS) Streptococcus pneumoniae α-Streptococcus(viridans group) Enterococcus
#27.
クイズ答え 血液培養1/2セットから発育したときに真の菌血症(>コンタミ)と考えられるのはどれでしょう? S. aureus CNS β-Streptococcus(GAS, GBS, GGS) Streptococcus pneumoniae α-Streptococcus(viridans group) Enterococcus
#28.
真の菌血症 or コンタミネーション The American Journal of Medicine. 2010;123:819-828 S. aureusは特に1/2セットでも真の菌血症と考えるべきです! 「CNSによるCRBSI」や「Viridans group StrepによるIE」という臨床推論が確からしい状況であれば,もちろん真の菌血症と考えて治療します
#29.
クイズ 血液培養2セットから発育したときに経胸壁心エコーを行うべきなのはどれでしょう? S. aureus CNS β-Streptococcus(GAS, GBS, GGS) Streptococcus pneumoniae α-Streptococcus(viridans group) Enterococcus
#30.
クイズ答え 血液培養から発育したときに経胸壁心エコーを行うのが望ましいのはどれでしょう? S. aureus CNS β-Streptococcus(GAS, GBS, GGS) Streptococcus pneumoniae α-Streptococcus(viridans group) Enterococcus
感染性心内膜炎の診断基準とリスク評価
#31.
感染性心内膜炎の診断基準(抜粋) Streptococcus viridansStreptococcus bovisHACEKグループStaphylococcus aureus他に感染巣がない市中感染のEnterococcus Staphylococcus aureusStaphylococcus lugdunensisEnterococcus faecalisS. pyogenes, S. pneumoniaeを除く全てのStreptococcusGranulicatella sp.Abiotrophia sp.Gemella sp.HACEKグループ Clin Infect Dis. 2023;ciad271
#32.
IEのリスクを見積もる(S. aureus) S. aureus菌血症でのIEリスク評価 Clin Infect Dis. 2022;74(8): 1442–1449.
#33.
IEのリスクを見積もる(S. aureus) カットオフはPOSITIVE>4, PREDICT≧2, VIRSTA≧3 Clin Infect Dis. 2022;74(8):1442–1449. 陰性的中率はいずれも高いため,カットオフ未満の点数しかない(=IEのリスクが低い)症例では,スクリーニングで経胸壁心エコーを施行して疣贅がなければ,IEは除外できると考えられる.陽性的中率や特異度が高いスコアのカットオフを超えている(=IEのリスクが高い)症例では,早急に経食道心エコーまで予定するべきと考えられる.
#34.
IEのリスクを見積もる(Streptococcus) 非β溶血性連鎖球菌菌血症でのIEリスク評価 Clin Infect Dis. 2018;66:693-698 →3点以上でIEに対する感度100%, 特異度74%
#35.
IEのリスクを評価する(Enterococcus) Clin Infect Dis. 2016;63:771Infection. 2019;47(1):45-50. ※イメージとしては,フォーカスのよくわからない,または播種病変を伴う腸球菌菌血症ではIEを鑑別に挙げましょう
#36.
結局心エコーの施行戦略は? S. aureus α-Streptococcus(viridans group) CNSβ-StreptococcusS. pneumoniae Enterococcus TTEは絶対行う.Scoreは除外には有用で,TEEを省略できる. HANDOC scoreは除外には有用で,TTEを省略できる. フォーカスが明らかで,播種病変もなければ,TTEを省略できる. 基本はTTE不要.播種病変や弁膜症/心臓内デバイスがある場合にはTTEを行う.
臨床ケーススタディと治療方針の検討
#37.
練習問題1 80歳女性.糖尿病,CKDG3の既往あり.下腿浮腫ありADL杖歩行. 39℃の発熱,悪寒戦慄,体動困難を主訴に救急外来を受診され,細菌尿とAKIがあり,腎盂腎炎の疑いでPIPC/TAZが開始された.入院2日後に尿培養からE. coli,入院3日後に血液培養1/2セットからStreptococcus dysgalactiaeが検出されたという報告が来た.解熱しており,腎機能もベースラインまで改善(CCr 35mL/min). →Next 診断名,今後の治療方針は?
#38.
練習問題1 答え # Streptococcus dysgalactiae(GGS)菌血症 # 蜂窩織炎# 無症候性細菌尿 下腿浮腫をよく観察すると,左下腿の方が腫脹・発赤しており,蜂窩織炎によるStreptococcus agalactiae菌血症と判断した.PIPC/TAZ→ABPC 2g div q8hにde-escalationを行い,IEの可能性が低い微生物かつ臨床経過であるため,心エコーは行わず,合計2週間の抗菌薬治療を行い退院とした.
#39.
練習問題2 75歳男性.糖尿病,moderate AS,前立腺肥大の既往あり.1ヶ月前に前立腺肥大の悪化のため経尿道的前立腺切除術(TUR-P)を施行された. 3週間前に発熱があり,近医内科を受診してLVFXを処方された.2週間前に腰痛があり,近医整形外科を受診してトラマドール・アセトアミノフェンを処方された.その後も腰痛が改善せず起居動作や歩行が自力ではできなくなったため,救急要請された. →Next 鑑別診断,行う検査,初期治療の方針は?
#40.
練習問題2 続き <鑑別診断> # 腰椎椎体炎疑い # 感染性心内膜炎疑い<検査> ・血液培養2セット ・腰椎MRI ・経胸壁心エコー<初期治療> 抗菌薬はあえて入れなくて良い (ここは人によって判断が分かれる所ですが,椎体炎・感染性心内膜炎の場合,原因微生物の特定が優先され,ショックや心不全など緊急性のある全身状態でなかったため)入院2日後血液培養2セット→Enterococcus faecalis腰椎MRI→L5/S1椎体炎・椎間板炎経胸壁心エコー→moderate AS, severe AR, A弁右冠尖のprolapse →Next 行う検査,抗菌薬治療の方針は?
#41.
練習問題2 答え 経食道心エコー→A弁 11mm×6mmの疣贅,severe AR # Enterococcus faecalisによる感染性心内膜炎+椎体炎ABPC 2g div q4h + CTRX 2g div q12h開始.疣贅が10mmを超えており,大動脈弁置換術施行. 術後6週間の点滴抗菌薬治療の後,残存する椎体炎の治療としてAMPC 500mg po TIDを継続し,外来フォロー.
#42.